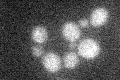
YBR295W

View description
Cadmium transporting P-type ATPase; may also have a role in copper and iron homeostasis; stabilized by Cd binding, which prevents ubiquitination; S288C and other lab strains contain a G970R mutation which eliminates Cd transport function
Localization:
Intensity:
Fold change:
Significance:
-
C’ GFP library in SD

below threshold14.55 -
N' NOP1pr-GFP in SD

N/A0 -
N' TEF2pr-mCherry in SD

N/A0 -
N' NATIVEpr-GFP in SD

N/A0 -
N' TEF2pr-VC and Cyto-VN in SD

N/A0 -
C’ GFP library in SD+DTT

cytosol17.521.2No -
C’ GFP library in SD+H2O2
cytosol16.261.11No -
C’ GFP library in Starvation Media

cytosol14.981.02No -
C’ GFP library on the background of Pup2-DaMP

N/A -
C’ GFP library on the background of CCT mutant

N/A0N/AYes
